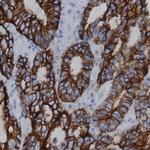
Phosphotyrosine Antibody in Immunohistochemistry (Paraffin) (IHC (P))

Search
AbboMax
Phosphotyrosine Monoclonal Antibody (7E11)
{{$productOrderCtrl.translations['antibody.pdp.commerceCard.promotion.promotions']}}
{{$productOrderCtrl.translations['antibody.pdp.commerceCard.promotion.viewpromo']}}
{{$productOrderCtrl.translations['antibody.pdp.commerceCard.promotion.promocode']}}: {{promo.promoCode}} {{promo.promoTitle}} {{promo.promoDescription}}. {{$productOrderCtrl.translations['antibody.pdp.commerceCard.promotion.learnmore']}}
图: 1 / 1
Phosphotyrosine Antibody (603-830) in IHC (P)
产品信息
603-830
种属反应
宿主/亚型
分类
类型
克隆号
抗原
偶联物
形式
浓度
纯化类型
保存液
内含物
保存条件
运输条件
产品详细信息
Positive control: A431 (EGF stimulated)
靶标信息
The role of tyrosine phosphorylation in transduction of the mitogenic signal from transmembrane receptors and in transformation by oncogene tyrosine kinases has been the subject of intense investigation for several years. While the phosphorylation of specific tyrosine residues has been shown to be a primary mechanism of signal transduction during normal mitogenesis, cell cycle progression and oncogenic transformation, its role in other areas such as differentiation and gap junction communication, is a matter of active and ongoing research. Antibodies that specifically recognize phosphorylated tyrosine residues have proved to be invaluable to the study of tyrosine -phosphorylated proteins and the biochemical pathways in which they function. The fluorescein (FITC) conjugate of clone PY20 anti-phosphotyrosine is especially useful for the detection of these P-Tyr proteins in immunohistochemical and immunocytochemical protocols in situations wherein the use of a secondary antibody would complicate detection of the protein(s) of interest.
仅用于科研。不用于诊断过程。未经明确授权不得转售。



